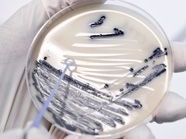

Seit Freitag wird im Wiener AKH eine deutsche Touristin behandelt, die an EHEC erkrankt ist. Wie die Generaldirektion des Krankenanstaltenverbunds am Samstag der APA mitteilte, werden erst am Dienstag die Untersuchungsergebnisse der AGES vorliegen, ob es sich um die aggressive Form des Keims handelt. Die 32-Jährige ist in einem stabilen Zustand.
Die Frau stammt aus dem von EHEC besonders betroffenen Bundesland Niedersachsen und war bereits mit entsprechenden Symptomen eingereist, berichtete Thomas Kvicala, Sprecher von Gesundheitsminister Alois Stöger.
Es dürfe sich wohl um eine Infektion mit den aggressiven EHEC-Bakterien (HUS) handeln, da die Nieren der Patientin betroffen sind. Klarheit werden aber erst die weitergehenden Untersuchungen des Keims ergeben. “Mittlerweile ist sie auf dem Weg der Besserung, sie ist ansprechbar“, betonte Kvicala.
Du hast einen Hinweis für uns? Oder einen Insider-Tipp, was bei dir in der Gegend gerade passiert? Dann melde dich bei uns, damit wir darüber berichten können.
Wir gehen allen Hinweisen nach, die wir erhalten. Und damit wir schon einen Vorgeschmack und einen guten Überblick bekommen, freuen wir uns über Fotos, Videos oder Texte. Einfach das Formular unten ausfüllen und schon landet dein Tipp bei uns in der Redaktion.
Alternativ kannst du uns direkt über WhatsApp kontaktieren: Zum WhatsApp Chat
Herzlichen Dank für deine Zusendung.